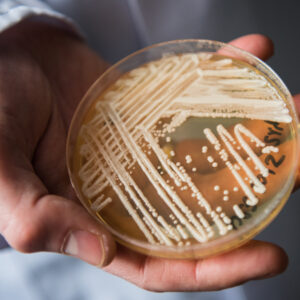
Посів; джіжджоподібні гриби; слизова; чутливість до 2-5 антимікотиків.
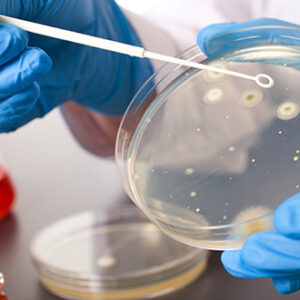
Посів; бактеріальна інфекція; шкіра; чутливість до 2-10 антибіотиків.

Показано 1–9 із 39Sorted by price: low to high
-

Посів виділень зі статевих органів; уреоплазмоз, мікоплазмоз; якісне визначення.
395.94 ₴ Додати в кошик -

Посів; джіжджоподібні гриби; слизова; чутливість до 2-5 антимікотиків.
411.16 ₴ Додати в кошик -

Посів; бактеріальна інфекція; шкіра; чутливість до 2-10 антибіотиків.
424.21 ₴ Додати в кошик -

Посів на гонорею з чутливістью до антибіотиків.
438.92 ₴ Додати в кошик -

Посів; грибкова інфекція; шкіра; чутливість до 2-5 антимікотиків.
498.69 ₴ Додати в кошик -

Посів; джіжджоподібні гриби; слизова; чутливість до 2-5 антимікотиків. Забір матеріалу зі шкіри та її придатків.
505.26 ₴ Додати в кошик -
Посів; джіжджоподібні гриби; слизова; чутливість до 6-10 антимікотиків.
510.63 ₴ Додати в кошик -

Посів виділень зі статевих органів; уреоплазмоз, мікоплазмоз; якісне визначення. Забір матеріалу з полових органів (чоловіки) .
512.21 ₴ Додати в кошик -
Посів; бактеріальна інфекція; шкіра; чутливість до 2-10 антибіотиків. Забір матеріалу зі шкіри та її придатків.
518.31 ₴ Додати в кошик